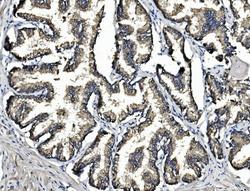

Antibody data
- Antibody Data
- Antigen structure
- References [0]
- Comments [0]
- Validations
- Western blot [1]
Submit
Validation data
Reference
Comment
Report error
- Product number
- A02244 - Provider product page

- Provider
- Boster Biological Technology
- Product name
- Anti-ARG2 Antibody Picoband™
- Antibody type
- Polyclonal
- Description
- Rabbit IgG polyclonal antibody for ARG2 detection. Tested with WB, IHC-P, ICC/IF, FCM, Direct ELISA in Human;Mouse;Rat.
- Reactivity
- Human, Mouse, Rat
- Host
- Rabbit
- Vial size
- 100μg/vial
- Concentration
- Add 0.2ml of distilled water will yield a concentration of 500ug/ml.
- Storage
- At -20°C for one year. After reconstitution, at 4°C for one month. It can also be aliquoted and stored frozen at -20°C for a longer time. Avoid repeated freezing and thawing.
- Handling
- Add 0.2ml of distilled water will yield a concentration of 500ug/ml.
No comments: Submit comment
Supportive validation
- Submitted by
- Boster Biological Technology (provider)
- Main image

- Experimental details
- Western blot analysis of ARG2 using anti-ARG2 antibody (A02244). Electrophoresis was performed on a 5-20% SDS-PAGE gel at 70V (Stacking gel) / 90V (Resolving gel) for 2-3 hours. The sample well of each lane was loaded with 50ug of sample under reducing conditions. Lane 1: human HEK293 whole cell lysates, Lane 2: human SW620 whole cell lysates, Lane 3: rat kidney tissue lysates, Lane 4: mouse kidney tissue lysates. After Electrophoresis, proteins were transferred to a Nitrocellulose membrane at 150mA for 50-90 minutes. Blocked the membrane with 5% Non-fat Milk/ TBS for 1.5 hour at RT. The membrane was incubated with rabbit anti-ARG2 antigen affinity purified polyclonal antibody (Catalog # A02244) at 0.5 μg/mL overnight at 4°C, then washed with TBS-0.1%Tween 3 times with 5 minutes each and probed with a goat anti-rabbit IgG-HRP secondary antibody at a dilution of 1:5000 for 1.5 hour at RT. The signal is developed using an Enhanced Chemiluminescent detection (ECL) kit (Catalog # EK1002) with Tanon 5200 system. A specific band was detected for ARG2 at approximately 39KD. The expected band size for ARG2 is at 39KD.
- Additional image